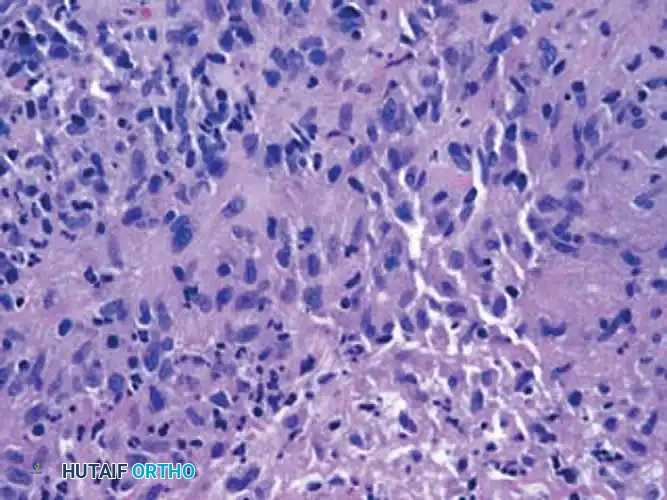
Image

Miscellaneous Hand Infections: Surgical Management
Key Takeaway
Miscellaneous and atypical hand infections, including necrotizing fasciitis, clostridial myonecrosis, and mycobacterial tenosynovitis, present severe diagnostic and therapeutic challenges. Prompt recognition, aggressive surgical debridement, and targeted antimicrobial therapy are paramount. This guide details the pathophysiology, clinical presentation, and step-by-step surgical management of these complex upper extremity infections to optimize patient outcomes and prevent catastrophic limb loss.
MISCELLANEOUS AND UNUSUAL INFECTIONS OF THE UPPER EXTREMITY
The management of hand and upper extremity infections typically revolves around common pyogenic organisms such as Staphylococcus aureus and Streptococcus species. However, the orthopedic surgeon must maintain a high index of suspicion for miscellaneous and atypical infections. These encompass a broad spectrum of pathology, ranging from self-limiting viral conditions to rapidly progressive, limb- and life-threatening necrotizing bacterial infections. Misdiagnosis or delayed intervention in these scenarios frequently results in catastrophic outcomes, including profound functional impairment, amputation, or mortality.
This comprehensive guide details the pathophysiology, clinical presentation, and rigorous surgical management of herpetic, intravenous drug-induced, immunocompromised, necrotizing, clostridial, and mycobacterial infections of the hand.
HERPETIC INFECTIONS (HERPETIC WHITLOW)
First described by Adamson in 1909, herpes simplex virus (HSV) infections of the hand—commonly termed herpetic whitlow—frequently mimic acute bacterial paronychia or felon. Recognizing this distinction is paramount, as the surgical management for pyogenic infections is strictly contraindicated in isolated herpetic lesions.
Pathophysiology and Epidemiology
Herpetic whitlow is predominantly caused by HSV types 1 and 2. The virus inoculates through a breach in the epidermis, leading to viral replication within the epithelial cells. It is an occupational hazard frequently observed in dental hygienists, respiratory therapists, and medical personnel exposed to oral or respiratory secretions. In the general population, it often occurs secondary to autoinoculation from concurrent herpes labialis or genital herpes.
Clinical Presentation
The infection most commonly involves the thumb and index finger, localizing to the paronychial region or the volar pad distal to the metacarpophalangeal (MCP) joint.
* Prodromal Phase: Localized pain, pruritus, and swelling precede visible lesions.
* Vesicular Phase: Clear, fluid-filled vesicles erupt and may coalesce into larger bullae. The fluid is highly infectious.
* Ulcerative Phase: Over approximately 2 weeks, vesicles rupture, leaving painful ulcers.
* Resolution Phase: Over the subsequent 7 to 10 days, the lesions crust and heal. However, viral shedding can persist, rendering the patient infective for up to 12 additional days.
Systemic symptoms, including axillary and epitrochlear lymphadenopathy with associated forearm lymphangitis, are common and should not be misconstrued as a spreading bacterial cellulitis.

Fig. 75-17 Vesicular eruption of dorsal aspect of proximal phalanx, left long fi nger. (From Sehayik RI, Bassett FH III: Herpes simplex infection involving the hand, Clin Orthop 166:138, 1982.)
Diagnostic Modalities
Diagnosis is primarily clinical, but laboratory confirmation is essential in atypical presentations:
1. Tzanck Smear: Rapid identification of multinucleated giant cells (does not differentiate HSV from varicella-zoster).
2. Viral Culture: The gold standard, though it requires several days for results.
3. Polymerase Chain Reaction (PCR): Highly sensitive and specific for HSV DNA.
4. Serology: Useful for confirming primary infections via acute and convalescent antibody titers.
Management Protocols
Surgical Warning: Routine incision and drainage (I&D) of an uncomplicated herpetic whitlow is strictly contraindicated. Surgical intervention can lead to viral dissemination, delayed healing, and secondary bacterial superinfection.
Medical Management:
* Antiviral Therapy: Oral acyclovir, valacyclovir, or famciclovir initiated within 48 hours of symptom onset can attenuate the clinical course.
* Wound Care: Dry dressings to prevent transmission and secondary bacterial contamination.
Surgical Indications:
Surgical intervention is reserved exclusively for cases complicated by a secondary pyogenic abscess. If a concomitant bacterial abscess forms (often S. aureus), a meticulous I&D is required.
* Technique: A limited incision is made directly over the fluctuant area, avoiding uninfected tissue planes. Intravenous antibiotics and systemic acyclovir must be administered concurrently.
INFECTIONS IN INTRAVENOUS DRUG ADDICTS (IVDA)
Hand infections in intravenous drug abusers present unique challenges due to the introduction of polymicrobial flora, particulate matter, and caustic substances into the subcutaneous tissues or vascular structures. The lack of asepsis during injection, combined with the extravasation of drugs ("skin popping"), leads to localized necrosis and severe sepsis.
Reyes Classification of IVDA Hand Infections
Reyes categorized these infections based on anatomical depth and prognostic severity:
* Type I: Confined to the skin and subcutaneous tissues (commonly dorsal fingers/hand).
* Type II: Involvement of the extensor tendon, with potential extension to the periosteum and bone.
* Type III: Involvement of the flexor tendon sheath (suppurative flexor tenosynovitis). This carries the worst prognosis for functional recovery.
* Type IV: Sequelae of inadvertent intra-arterial injection, resulting in severe vasospasm, digital ischemia, necrosis, and intractable pain.
Surgical Management
Clinical Pearl: Dorsal hand swelling in an IV drug user may be secondary to chronic lymphedema and fibrosis ("puffy hand syndrome") rather than acute infection. Careful clinical evaluation for fluctuance, erythema, and acute pain is required before committing to surgery.
Step-by-Step Surgical Approach:
1. Preparation: Hospitalization is mandatory. Obtain aerobic, anaerobic, and fungal cultures. Initiate broad-spectrum IV antibiotics (e.g., Vancomycin and Piperacillin-Tazobactam).
2. Tourniquet Control: Exsanguination via elevation rather than an Esmarch bandage is preferred to prevent proximal seeding of the infection.
3. Incision and Drainage: Utilize extensile incisions. For dorsal abscesses, longitudinal incisions are preferred to preserve venous and lymphatic drainage. For Type III infections, standard Brunner or mid-axial incisions are utilized for complete exposure of the flexor tendon sheath.
4. Débridement: Aggressively excise all necrotic skin, subcutaneous tissue, and non-viable tendon.
5. Lavage: Copious low-pressure irrigation with normal saline.
6. Wound Management: Wounds must be left open. Pack loosely with moist gauze.
7. Postoperative Care: Splint the hand in a safe position (intrinsic plus). Perform multiple daily dressing changes or utilize negative pressure wound therapy (NPWT). Early progressive rehabilitation is critical once the infection is controlled.
INFECTIONS IN IMMUNOCOMPROMISED (HIV/AIDS) PATIENTS
Patients with Acquired Immunodeficiency Syndrome (AIDS) or AIDS-related complex exhibit altered host responses, leading to atypical presentations of common infections and susceptibility to opportunistic pathogens.
Clinical Characteristics
Glickel’s landmark 1988 review highlighted the virulent and atypical nature of hand infections in this cohort:
* Herpetic Infections: Often fail to resolve spontaneously, presenting as deep, necrotic ulcers requiring prolonged intravenous antiviral therapy.
* Bacterial Abscesses: Dorsal bacterial abscesses may not respond to standard early drainage and have a high propensity to progress rapidly to osteomyelitis.
* Diagnostic Suspicion: An unusually severe, refractory, or atypical hand infection in a patient with unknown HIV status should prompt immediate serological testing and immunological workup (CD4 count, viral load).
NECROTIZING FASCIITIS
Historically termed "hospital gangrene," necrotizing fasciitis is a rapidly progressive, life-threatening bacterial infection characterized by widespread necrosis of the superficial fascia and subcutaneous tissue, with relative sparing of the underlying muscle in the early stages.
Microbiology and Giuliano Classification
- Type 1 (Polymicrobial): Accounts for the majority of cases. Involves synergistic infection by non-Group A streptococci, Enterobacteriaceae (E. coli, K. pneumoniae), and anaerobes (Bacteroides). Often seen in diabetics and immunocompromised hosts.
- Type 2 (Monomicrobial): Caused by Group A Streptococcus (GAS), occasionally in combination with Staphylococcus aureus (including MRSA). Can occur in young, healthy individuals following minor trauma.
Pathophysiology and Clinical Course
The infection spreads rapidly along fascial planes. Bacterial toxins and local ischemia lead to fascial liquefaction. Thrombosis of the nutrient perforating vessels results in secondary ischemia and necrosis of the overlying skin.
- Early Signs: Erythema, swelling, and pain out of proportion to physical findings. The skin may initially appear deceptively normal. Systemic signs (fever, leukocytosis) may be absent early on.
- Late Signs: Non-pitting edema, skin bullae (hemorrhagic), ecchymosis, crepitus (subcutaneous gas), and cutaneous anesthesia (due to destruction of superficial nerves).
- Systemic Collapse: If left untreated, it rapidly progresses to septic shock, disseminated intravascular coagulation (DIC), multi-organ failure, and death. Proximal spread to the chest wall carries a mortality rate exceeding 75%.
Surgical Technique: Radical Débridement
Surgical Warning: Time is tissue. Delaying surgery for advanced imaging (e.g., MRI) in a clinically obvious case of necrotizing fasciitis is a fatal error. Immediate surgical exploration is both diagnostic and therapeutic.
- Incision: Make generous, longitudinal extensile incisions over the affected area.
- The "Finger Test": Upon incising the deep fascia, a lack of bleeding, presence of foul-smelling "dishwater" pus, and the ability to easily sweep a gloved finger along the fascial plane (loss of normal tissue resistance) confirms the diagnosis.
- Excision: Radically excise all necrotic skin, subcutaneous fat, and liquefied fascia until healthy, bleeding tissue is encountered. Do not compromise the debridement to save skin flaps; inadequate excision is the primary cause of mortality.
- Muscle Assessment: While primarily a fascial disease, secondary myonecrosis can occur. Assess muscle viability using the "4 Cs": Color, Consistency, Contractility, and Capacity to bleed. Excise any dead muscle.
- Wound Management: Leave the wound entirely open. Apply bulky, absorbent dressings or NPWT.
- Second Look: Mandatory return to the operating room every 24 to 48 hours for re-exploration and further debridement until the infection is definitively halted.
- Reconstruction: Once a healthy granulating bed is established, closure is achieved via split-thickness skin grafting (STSG) or flap coverage. Amputation may be necessary as a life-saving measure if the infection cannot be controlled.
Antimicrobial and Adjunctive Therapy
- Empiric Antibiotics: Broad-spectrum coverage is mandatory. A common regimen includes a Carbapenem (or Piperacillin-Tazobactam) + Vancomycin + Clindamycin (added for its antitoxin effect against Group A Strep).
- Hyperbaric Oxygen (HBO): Controversial but may be utilized as an adjunct for difficult anaerobic infections, provided it does not delay surgical debridement.
GAS GANGRENE (CLOSTRIDIAL MYONECROSIS)
Gas gangrene is a fulminant, rapidly fatal infection characterized by profound myonecrosis, gas production, and overwhelming sepsis.
Microbiology and Pathogenesis
The primary pathogen is Clostridium perfringens, an anaerobic, spore-forming, gram-positive rod ubiquitous in soil and the human gastrointestinal tract. In conditions of low oxygen tension (e.g., crush injuries, devascularized tissue, tight primary closure of contaminated wounds), spores germinate into vegetative bacilli and release potent exotoxins:
* Alpha Toxin (Lecithinase): Causes profound myonecrosis, hemolysis, and platelet destruction.
* Theta Toxin: Causes hemolysis and cardiotoxicity.
* Kappa, Nu, and Mu Toxins: Facilitate rapid tissue breakdown and spread.
MacLennan Classification
- Type 1 (Contamination): Positive culture without clinical infection.
- Type 2 (Clostridial Cellulitis): Infection of subcutaneous tissue producing foul-smelling gas, but sparing the muscle. No severe systemic toxicity.
- Type 3 (Clostridial Myonecrosis): True gas gangrene. Rapid muscle destruction, severe systemic toxemia, and shock.
Clinical Presentation
The onset is abrupt, often within 24 hours of injury. The patient experiences sudden, severe, and unrelenting pain. The limb becomes rapidly edematous. Skin changes progress from pallor to bronze discoloration, followed by hemorrhagic bullae. A thin, sweet-smelling (or foul) exudate is present. Palpable crepitus is a late sign. Systemic collapse, characterized by tachycardia out of proportion to fever, hemolysis, and renal failure, ensues rapidly.
Surgical Management
- Immediate Radical Débridement: This is a surgical emergency. All necrotic and questionably viable muscle must be excised.
- Fasciotomy: Extensive fasciotomies of all compartments in the affected limb are required to decompress the tissue and alter the anaerobic environment.
- Amputation: Guillotine amputation is frequently required to save the patient's life if myonecrosis is extensive or systemic shock is profound.
- Wound Care: All wounds, including amputation stumps, must be left strictly open.
- Antibiotic Therapy: High-dose intravenous Penicillin G remains the drug of choice, often combined with Clindamycin (for toxin suppression) and a broad-spectrum agent (e.g., a cephalosporin or aminoglycoside) to cover concomitant aerobic contaminants.
MYCOBACTERIAL INFECTIONS
Mycobacterial infections of the hand are indolent, chronic, and frequently misdiagnosed. They are broadly divided into Mycobacterium tuberculosis and Nontuberculous Mycobacteria (NTM).
Tuberculosis (M. tuberculosis)
While pulmonary TB is most common, extrapulmonary manifestations in the hand typically present as tenosynovitis, osteomyelitis, or septic arthritis.
- Tuberculous Tenosynovitis: Often presents as a chronic, painless swelling of the volar wrist and palm, classically described as a "compound palmar ganglion." The hypertrophic synovium can cause secondary compression of the median nerve within the carpal tunnel.
- Surgical Management: Treatment requires a combination of systemic multidrug antituberculous therapy (RIPE regimen) and meticulous surgical tenosynovectomy. The flexor retinaculum is released, and the granulomatous tissue (often containing "rice bodies") is meticulously excised from around the flexor tendons to prevent tendon rupture.
- Osteoarticular TB: May require joint debridement, curettage of bone lesions, and eventual arthrodesis.
Nontuberculous Mycobacteria (NTM)
Mycobacterium marinum is the most common NTM infecting the hand, classically causing "fish tank granuloma." Infection occurs via inoculation of the bacteria through an abrasion while handling contaminated aquatic environments (fish tanks, swimming pools, marine life).

Clinical presentation of a chronic, poorly healing nodular lesion on the dorsum of the hand, typical of Mycobacterium marinum infection.
Clinical Presentation:
Presents as a chronic, poorly healing, violaceous nodule or ulcer, typically on the dorsum of the hand or fingers. It can progress to deep structure involvement, causing chronic tenosynovitis or septic arthritis. Sporotrichoid spread (nodules ascending along lymphatic drainage pathways) may occur.
Diagnosis:
Clinical Pearl: Routine bacterial cultures will be negative. If NTM is suspected, the laboratory must be explicitly instructed to culture the tissue specimen on Lowenstein-Jensen medium at 30°C to 32°C, as these organisms do not grow at standard core body temperatures (37°C).
Histological section demonstrating granulomatous inflammation with multinucleated giant cells, characteristic of mycobacterial infection.
Management:
* Medical: Prolonged antimicrobial therapy (often 3 to 6 months) is required. Regimens typically include Clarithromycin, Ethambutol, or Rifampin, guided by susceptibility testing.
* Surgical: Superficial skin lesions may resolve with antibiotics alone. However, deep infections involving the tenosynovium or joints require thorough surgical debridement and synovectomy to eradicate the disease and prevent structural damage.
You Might Also Like
